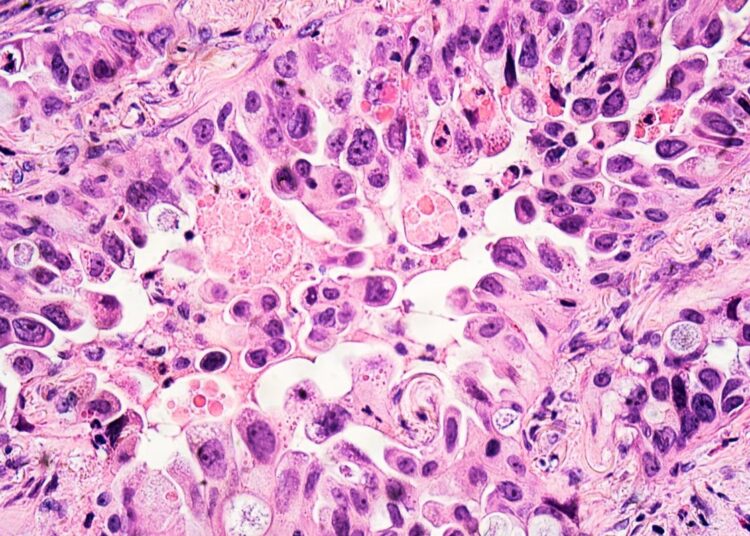
Study: The effect of COVID-19 mRNA vaccine on respiratory system: human lung carcinoma cells by means of Raman spectroscopy and imaging. Image Credit: David A Litman/Shutterstock

La maladie à coronavirus 2019 (COVID-19) s’est propagée dans presque tous les pays du monde et a causé plus de 5 millions de décès. Suite à l’émergence de la souche initiale à Wuhan, en Chine, et à sa propagation internationale soudaine, de nombreux gouvernements ont choisi de promulguer des mesures coûteuses et restrictives pour empêcher le nombre de reproduction rapide et alarmant du coronavirus 2 du syndrome respiratoire aigu sévère (SRAS-CoV-2) d’augmenter plus haute.
Étude : L’effet du vaccin COVID-19 d’ARNm sur le système respiratoire : cellules humaines de carcinome de poumon au moyen de la spectroscopie et de la représentation de Raman. Crédit d’image : David A Litman/Shutterstock
Ces mesures ont été lentement démantelées une fois que plusieurs vaccins différents ont été produits et administrés dans les pays développés. Cependant, il reste des menaces provenant de nouvelles variantes et la plupart des pays en développement n’ont pas de populations vaccinées. Des chercheurs de l’Université de technologie de Lodz ont étudié les effets des vaccins à ARNm COVID-19 sur les cellules de carcinome pulmonaire humain.
Une version préimprimée de l’étude est disponible sur le bioRxiv* serveur pendant que l’article est soumis à un examen par les pairs.
L’étude
L’imagerie Raman a permis aux scientifiques d’étudier les composants cellulaires sans ouvrir la cellule. Les cytochromes peuvent être classés en fonction de la bande d’absorption d’énergie électronique la plus faible dans leur état réduit, ce qui permet de distinguer les différents cytochromes. L’excitation laser avec une longueur d’onde de 532 nm avec l’énergie en coïncidence avec l’absorption électronique de la bande Q peut conduire à une intensité accrue de la diffusion Raman qui permet d’étudier le cytochrome c à de faibles concentrations dans les mêmes conditions physiologiques que les humains.
Le cytochrome c est situé dans les membranes mitochondriales internes entre le complexe III et le complexe IV, et il est important dans la chaîne de transport d’électrons. Il existe normalement sous forme oxydée et est réduit lors de la respiration. Les spectres Raman sont excellents pour les marqueurs de l’état redox du cytochrome c, car les signaux Raman de la forme réduite sont significativement plus élevés que la forme oxydée.
Les chercheurs ont démontré qu’il n’y a pas de libération de cytochrome c dans le cytoplasme des cellules cancéreuses du poumon. Le nombre de mitochondries dans une seule cellule a diminué lors de l’incubation avec l’ARNm qui détermine leurs activités métaboliques. Les résultats de l’imagerie Raman initiale ont prouvé que le vaccin à ARNm ne bloque pas le transfert d’électrons entre les complexes III et IV de la chaîne respiratoire mais diminue le nombre de mitochondries dans les cellules, ce qui démontre des besoins métaboliques plus faibles et une efficacité moindre de la phosphorylation oxydative et Synthèse d’ATP. Un effet similaire a été observé dans les cellules cancéreuses du cerveau.
Les scientifiques ont ensuite observé la localisation du cytochrome c dans le cytoplasme pour vérifier si la concentration plus faible était liée à l’apoptose. Ils ont utilisé l’imagerie Raman pour montrer l’effet du vaccin à ARNm sur le cytoplasme du carcinome pulmonaire humain, qui a montré que le signal pour les cellules témoins et les cellules incubées avec le vaccin à ARNm COVID-19 était le même. Cela montre que la concentration plus faible du cytochrome dans les mitochondries n’est pas causée par une libération dans le cytoplasme – ce qui pourrait déclencher l’apoptose.
Les chercheurs se sont ensuite concentrés sur la synthèse des lipides dans les cellules incubées avec le vaccin à ARNm. Ils ont montré que le cytochrome c était significativement modifié suite à l’incubation. Les signaux correspondant aux vibrations de flexion CH des lipides dans le réticulum endoplasmique rugueux et les gouttelettes lipidiques ont augmenté de manière significative. Cela pourrait indiquer que l’ARNm modifie le métabolisme des lipides suite à une régulation positive par la synthèse des lipides de novo.
Les gouttelettes lipidiques dans les cellules normales sont remplies d’esters de rétinyle/rétinol et sont fortement impliquées dans la signalisation. Les scientifiques ont émis l’hypothèse que l’incubation avec l’ARNm augmente le rôle de la signalisation. Les scientifiques ont cherché des indications que l’ARNm pouvait pénétrer dans le noyau mais, comme prévu, n’ont rien trouvé. Ils n’ont également trouvé aucune indication significative de changements dans les interactions à la surface des cellules.
La conclusion
Malgré l’absence de changements observés dans le noyau de la cellule, les auteurs suggèrent que le vaccin à ARNm modifie la cellule de manière similaire au cancer, ajoutant la mise en garde que cela n’affecte que le cytochrome c et les lipides. Les données présentées suggèrent une altération du comportement des cellules.
Pourtant, la conclusion agressive pourrait facilement être mal interprétée et utilisée comme carburant pour les croyances anti-vaccination, même si aucun des changements observés dans ces cellules ne pouvait être transmis aux cellules filles. En plus de cela, les niveaux de vaccin dans lesquels les cellules ont été incubées étaient significativement plus élevés que la plupart des cellules connaîtront après la vaccination. Bien que la conclusion dépasse de manière significative, les informations sur l’effet du vaccin sur les mitochondries et les lipides cellulaires sont précieuses et pourraient aider à informer les fabricants de vaccins à l’avenir.
*Avis important
bioRxiv publie des rapports scientifiques préliminaires qui ne sont pas évalués par des pairs et, par conséquent, ne doivent pas être considérés comme concluants, guider la pratique clinique/les comportements liés à la santé, ou traités comme des informations établies.